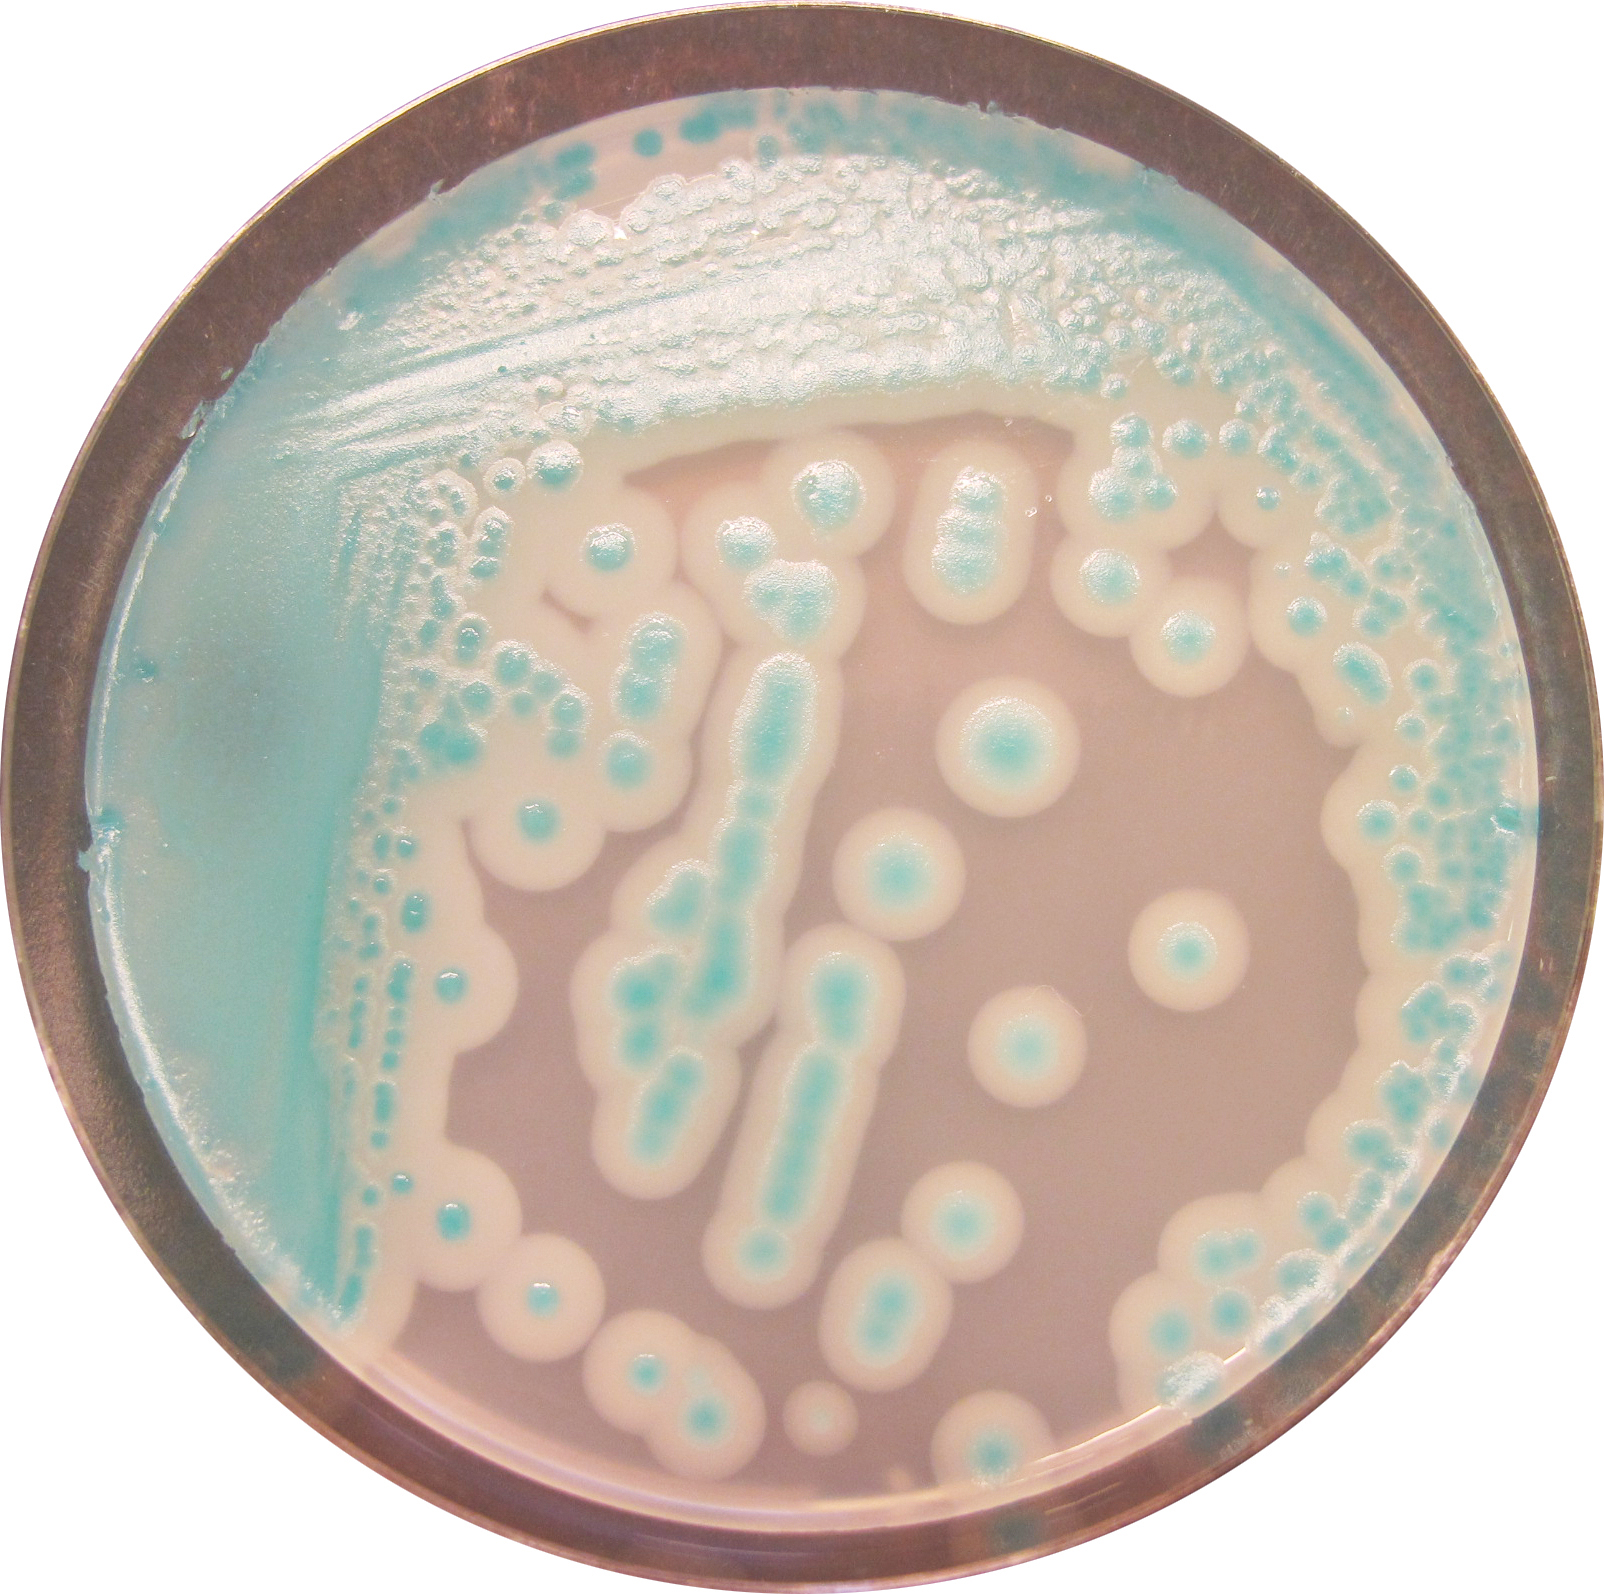

Tối Ưu An Toàn Sinh Học Ngành Sữa: Vai Trò Của CHROMagar B. cereus Trong Nhận Diện Sớm Bacillus cereus
Môi trường CHROMagar B. cereus được xem như là một giải pháp sàng lọc tiên phong trong quy trình kiểm soát an toàn sinh học cho chuỗi sản xuất sữa trẻ em.
Độc Tố Cereulide Trong Chuỗi Cung Ứng Sữa: Thách Thức Độc Học Ty Thể Và Chiến Lược Kiểm Soát Đa Tầng
Trong lĩnh vực an toàn thực phẩm hiện đại, sự trỗi dậy của các độc tố bền nhiệt đang đặt ra những thách thức nghiêm trọng đối với quy trình chế biến công nghiệp truyền thống. Trong số đó, Cereulide — một loại độc tố gây nôn (emetic toxin) được sản sinh bởi vi khuẩn Bacillus cereus — đang trở thành mối đe dọa trực tiếp đến chuỗi cung ứng sữa toàn cầu, đặc biệt là các sản phẩm dành cho đối tượng nhạy cảm như trẻ sơ sinh.
1. Nghịch lý giữa Công nghệ chế biến và Độ bền sinh hóa
Khác biệt hoàn toàn với các tác nhân vi sinh thông thường, Cereulide sở hữu một cấu trúc hóa học đặc thù là một depsipeptide vòng, mang lại khả năng sinh tồn ngoại hạng trước các tác động vật lý và hóa học. Các nghiên cứu thực nghiệm đã chứng minh rằng Cereulide có thể duy trì hoạt tính sinh học ngay cả khi tiếp xúc với nhiệt độ 121°C trong vòng 90 phút (Rajkovic et al., 2008). Điều này dẫn đến một nghịch lý trong công nghệ thực phẩm: các quy trình tiệt trùng tiêu chuẩn như Pasteurization hay UHT có thể tiêu diệt hoàn toàn vi khuẩn mẹ B. cereus nhưng lại hoàn toàn vô hiệu trước độc tố Cereulide đã hình thành trước đó.
2. Kiểm soát nguồn phát thải sinh học bằng môi trường CHROMagar B. cereus
Để ngăn chặn sự hình thành độc tố, chiến lược phòng thủ phải được thiết lập ngay từ khâu tiếp nhận nguyên liệu và kiểm soát môi trường sản xuất. Trong bối cảnh đó, việc ứng dụng các môi trường nuôi cấy chromogenic hiện đại như CHROMagar B. cereus đóng vai trò là một công cụ sàng lọc then chốt.
Khác với các môi trường truyền thống (như MYP hay Mossel) vốn thường gặp khó khăn trong việc phân biệt các loài thuộc nhóm B. cereus và dễ bị nhiễu bởi hệ vi sinh vật đi kèm, CHROMagar B. cereus cho phép định danh trực tiếp thông qua màu sắc đặc trưng (xanh lam đến xanh lục) nhờ các cơ chất tạo màu chuyên biệt. Công cụ này giúp các nhà máy sản xuất sữa trẻ em rút ngắn thời gian phân tích, tăng độ nhạy trong việc phát hiện các chủng B. cereus tiềm năng gây độc, từ đó ngăn chặn sự tích lũy Cereulide trong dây chuyền chế biến ngay từ giai đoạn sớm (CHROMagar, 2024).
Hình. Môi trường CHROMagar B. cereus
3. Độc học ty thể và tính nhạy cảm của trẻ sơ sinh
Về mặt độc học, Cereulide được xác định là một ionophore vận chuyển kali có ái lực cao. Khi xâm nhập vào tế bào, nó gây ra hiện tượng mất phân cực màng ty thể, ức chế quá trình oxy hóa phosphoryl hóa và làm cạn kiệt nguồn năng lượng ATP. Đối với trẻ sơ sinh dưới 6 tháng tuổi, hệ quả này trở nên trầm trọng hơn do hệ thống enzyme gan và thận chưa hoàn thiện, dẫn đến sự tích tụ độc tố và gây ra các hội chứng suy gan cấp tính hoặc rối loạn chuyển hóa nghiêm trọng (Sarkar et al., 2023). Sự cố thu hồi sữa quy mô lớn của các tập đoàn thực phẩm hàng đầu như Nestlé và Danone trong giai đoạn 2025-2026 là minh chứng cho thấy các rủi ro này đã trở thành các biến cố thực tế đe dọa sức khỏe cộng đồng.
4. Sự chuyển dịch sang Kỹ thuật định lượng vết (LC-MS/MS)
Sự hiện diện của "độc tố nấp bóng" — tức trường hợp thực phẩm không còn vi khuẩn sống nhưng vẫn chứa độc tố — đòi hỏi một sự thay đổi căn bản trong tư duy kiểm nghiệm. Khi các công cụ sàng lọc như CHROMagar B. cereus đưa ra cảnh báo về mật độ vi khuẩn vượt ngưỡng, việc khẳng định và định lượng độc tố phải được thực hiện bằng các kỹ thuật tiên tiến. Ngành công nghiệp sữa đang chuyển dịch mạnh mẽ sang việc ứng dụng kỹ thuật sắc ký lỏng ghép nối khối phổ hai lần (LC-MS/MS) theo tiêu chuẩn ISO 18465:2017.
Việc triển khai các hệ thống UHPLC-MS/MS cho phép định lượng Cereulide ở ngưỡng phần tỷ (ppb), đảm bảo rằng ngay cả những dấu vết độc tố nhỏ nhất cũng bị phát hiện. Sự kết hợp giữa sàng lọc nhanh bằng môi trường chuyên biệt và định lượng chính xác bằng khối phổ chính là mô hình quản trị rủi ro sinh học toàn diện, thiết lập hàng rào bảo vệ vững chắc cho sức khỏe trẻ sơ sinh.
Tài liệu tham khảo trích dẫn:
-
CHROMagar (2024). CHROMagar B.cereus: For detection and enumeration of Bacillus cereus group members.
-
EFSA (2026). Precautionary global recall of infant nutrition products following detection of Bacillus cereus.
-
ISO 18465:2017. Microbiology of the food chain — Quantitative determination of emetic toxin (cereulide) using LC-MS/MS.
-
Rajkovic, A., et al. (2008). Heat resistance of Bacillus cereus emetic toxin cereulide. Letters in Applied Microbiology.
-
Sarkar, A., et al. (2023). Mechanism of toxicity: Cereulide as a potassium ionophore and its effect on mitochondria. Food Research International Briefs.
-
Zheng, L., et al. (2023). A better understanding of the impact of Bacillus cereus and cereulide on public health. Foods.

CÔNG TY TNHH KHOA HỌC KỸ THUẬT TOÀN CẦU
Trụ sở: Lầu 19, khu A, số 4 Nguyễn Đình Chiểu, Phường Đa Kao, Quận 1, TP. Hồ Chí Minh, Việt Nam
VP HCM: 48 Châu Thị Hóa, Phường 4, Quận 8, TP. Hồ Chí Minh
VP HN: Số nhà 59B ngõ 148 Trần Duy Hưng, phường Trung Hòa, Quận Cầu Giấy, Hà Nội
Hotline: 0908.090.555
Email: dinh@global.net.vn
Website: https://globallab.com.vn/
Xem thêm